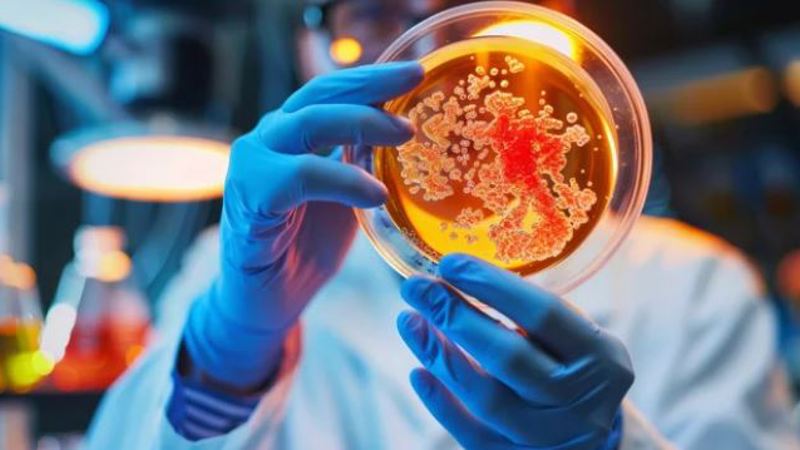

Innovative Testing Solutions Since 2011
The top exporters and the New Zealand government highly value our extensive research and development capabilities and comprehensive testing abilities.
We are constantly exploring ways to assist our customers in expanding into new markets, and we are always open to discussing these opportunities with them. Our testing services are known for delivering significant advancements in speed, affordability, and quality, revolutionizing the industries we operate in.
-

Honey
ALS Food and Environmental NZ's (formerly Analytica) honey testing service provides fast and cost effective options for the high volume tests needed by beekeepers, manufacturers, and marketers. We are fully accredited under IANZ 17025 and are MPI RLP approved for stress free exporting of your honey when you use our lab.
-

Dairy
ALS Food and Environmental NZ (formerly Analytica) offers specialised testing of milk and dairy products for functional components, micro-organisms and pathogens, residues, and contaminants. Our senior technical staff regularly support R&D projects in milk and dairy products, allowing us to provide solutions that are not available from other providers.
-

Food Testing
ALS Food & Environmental NZ (formerly Analytica) offers a range of IANZ ISO 17025 accredited microbiology and pathogen detection tests for different foodstuffs. We take the guesswork out of food safety by helping you ensure your product is safe to consumers.
-
Hygiene & Environmental Monitoring
ALS Food & Environmental NZ (formerly Analytica) is the first commercial laboratory in New Zealand to offer Rapid Multi-Pathogen Testing – rapid detection of 5 pathogens from only 2 swabs! We also offer other pathogen and indicator microorganism monitoring options to help with trouble-shooting causes of contamination.
-

R&D
ALS Food and Environmental NZ (formerly Analytica) has the staff and equipment to provide unique solutions that those involved in research and product development need to make their projects a success. From design of experiments, to development of methods on our wide range of analytical testing equipment, we are ready to listen to what you want to achieve and provide you with a proposal that will meet your needs. Our specialty areas are metabolomics and proteomics.
-

Water
ALS Food and Environmental NZ's (formerly Analytica) water testing services are playing a crucial role in addressing the increasing concern for water quality in New Zealand. These services are aiding the efforts of government agencies, business owners, and individuals in accurately assessing and effectively managing the quality of water that holds significance for them.
-

Environmental
Analytica's environmental testing services showcase the unique and innovative approach that sets our company apart. We have been dedicated to developing these services since 2014 and introduced our comprehensive range of testing to the NZ market in 2016. Our offerings include IANZ/ISO 17025 accreditation for organic and inorganic testing of waters and soils, as well as strategic partnerships to meet the diverse needs of our customers.
-

Methamphetamine & Lead
Our methamphetamine (and precursor) testing provides information about drug residues from residential and commercial properties and motor vehicles. Both the manufacture and smoking of methamphetamine will leave residues. When buying or selling property, test results are helpful when agreeing on a property’s value. Landlords and their tenants can use results to confirm that the rented property is safe to live in, and that drugs have not been used during a tenancy.
-

Asbestos
Analytica Laboratories provides a full range of asbestos testing in our Christchurch laboratory.
- MethSafe Ltd -
ANALYTICA DIRECT
Analytica Direct is our online customer dashboard, allowing users to:
- Quickly view test status, anytime.
- Access results, before jobs are completed.
- Automatically receive results using an API.
- Filter and save results to suit your needs.
- Access historical reports and data on demand.
- Set multiple user permissions to access accounts and view results.

ALS Environmental NZ - Hawkes Bay
ALS Environmental NZ - Hawkes Bay (Formerly Water Testing Hawke’s Bay) is one of New Zealand's leading regional bacteriological water-testing and analysis laboratories.





